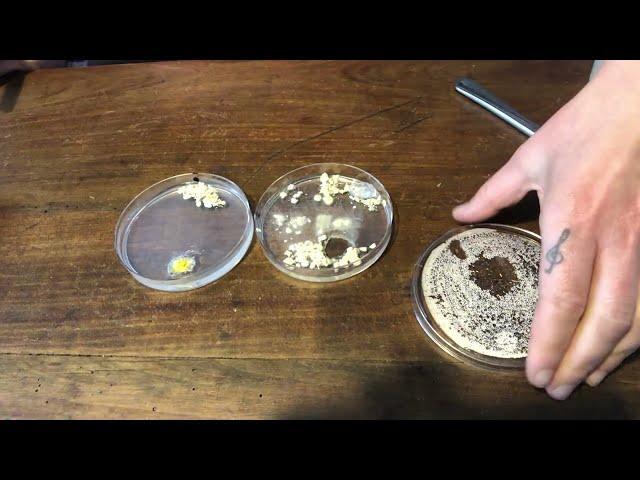

Le blob 4 - tuto: comment changer une gélose
Комментарии:
Le blob 4 - tuto: comment changer une gélose
Aude et Sébastien V
The TRAGIC death of Alan Ladd!
Pop Buzz
Shatta Wale - Eye Red (Lyrics)
soak inn
Learn How your BRAIN Works
Dr Sid Warrier
Pure Weekend Sports | 01-03-2025
Pure Fm TV
The Google Monopoly is Crumbling
Mental Outlaw


























